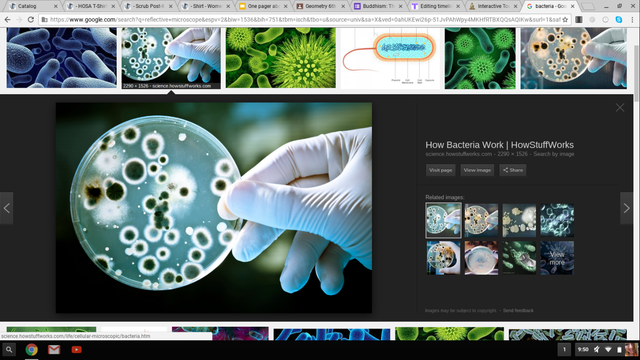
Renaissance

-
Antonie van Leeuwenhoek describes bacteria
-
The use of the scientific method begins
-
Egyptian Papyrus
-
Frenchwoman Jacoba Felice tries to practice medicine but is denied.
-
Attributed health and illness to the gods natural remedies, medicine and religion frequently intertwined
-
Aesculapius Greek god of healing
Caduceus is the symbol of medicine -
Greek book of epidemics
-
Hippocratic Oath
-
Galen; Tracheotomy
-
Rhazes discovered difference between smallpox and measles
-
Islamic hospitals; health care for the sick
-
Francis Bacon uses microscope to discover plague fleas
-
Edward Jenner discovered first vaccination
-
Ignaz Semmelweis shows importance of hand washing
-
Salk discovers polio vaccine
-
HMO declares smallpox eradicated
-
Steve Thomas used sterile maggots for infectious wound treatment
-
Robert Hooks- reflective microscope
-
John Snow stops outbreak of Cholera
-
AZT is used to combat AIDS
-
Louis Pasteur pasteurization of milk
-
Joseph Lister- practice of medical asepsis
-
Robert Knoch- discovery of pathogens
-
Marie Curie discovers science of radioactivity
-
Bubonic Plague hits San Fransisco
-
First HMO insurance
-
Alexander Flaring discovers penicillin
-
Managed health care; growth in uninsured
Want to make a timeline like this?
Use Timetoast to turn dates, events, milestones, and phases into a clear visual timeline you can build and share. Timetoast is a timeline maker for work, school, research, and stories.